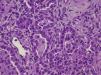

Respiratory distress syndrome (RDS) is due to surfactant deficiency and commonly occurs in preterm neonates. Recent studies indicate that mutations in the gene encoding for the ATP-binding cassette protein A3 (ABCA3) are a significant cause of neonatal respiratory distress in full-term neonates with surfactant deficiency.1
We present the clinical course of a male newborn with homozygous ABCA3 gene mutation, who was kept alive for 2 months with extracorporeal life support. He was the second child of Romanian parents in Portugal, had had no prenatal care assessment until 34 weeks when infectious screening showed negative serologies and vaginal group B Streptococcus carriage. Eutocic delivery at 36 weeks of gestational age, weighed 2880 grams and had Apgar score 9/10/10. Fifteen minutes after delivery the newborn developed respiratory distress and was started on Continuous Positive Airway Pressure and on antibiotics. A left-sided pneumothorax was diagnosed, treated successfully with thoracocentesis, allowing for spontaneous breathing with oxygen therapy (5l/min).
At 36h of life the chest X-ray (CXR) showed respiratory distress syndrome type II and surfactant was administered. Around 40h of life, due to increasing dyspnea, he was started on high frequency oscillatory ventilation and inhaled nitric oxide and transferred to a level III Neonatal Intensive Care Unit, but clinical deterioration continued. On day 5 he had severe pulmonary hypertension and refractory respiratory failure and our extracorporeal membrane oxygenation (ECMO) referral center retrieved him on veno-arterial ECMO.
After 2 weeks of ECMO and persistent interstitial opacity on the CXR (Fig. 1), the infectious etiology was questioned and further investigation was undertaken. Computed tomography revealed diffuse reticular-nodular infiltrates and ground glass opacity in the lungs. Bronchoalveolar lavage revealed a mixed inflammatory pattern, without signs of alveolar proteinosis and tested negative for cytomegalovirus, Legionella pneumophila, Pneumocystis jirovecii and fungus.
Considering these clinical and imaging findings, negative culture results and absence of response to antibiotics, the most likely scenario was that of an interstitial lung disease, namely a surfactant protein disorder. Blood was sent for genetic tests and specific treatment was empirically started: prednisolone, hydroxychloroquine and azithromycin.
An improvement in the lung volumes on day 41 propelled a therapeutic trial with lung surfactant. During the following 12h lung volumes increased to around 6ml/kg and the interstitial opacity on CXR decreased. Unfortunately the effect did not last more than 12h. The experience was repeated 24h later with similar results.
On day 56 the genetic test results came through: DNA sequencing demonstrated a homozygous mutation in ABCA3 gene: c.3997_3998del (p.Arg1333Glyfs*24).Empiric treatment was discontinued and, on day 61, following a comprehensive discussion with the parents, intensive care was withdrawn.
After death lung and skin biopsies were performed, with written consent from the parents. The lung biopsy revealed chronic pneumonitis of the infant (Fig. 2).
Mutations of ABCA3 gene are a rare differential diagnosis of RDS in newborn, initially thought to cause fatal lung disease in term neonates, but now recognized as a cause of chronic interstitial lung disease in pediatric patients.2,3 More than 150 distinct mutations have been identified, so the high frequency of ABCA3 mutations among term and late preterm RDS infants of European descent (estimated frequency at ∼1 in 3100) suggest that these mutations account for a portion of disease heritability,4 especially in homozygous mutations.5,6 In this case consanguinity was denied, but the parents were Romanian gypsies from the same region, which increases the likelihood of family connections.
There are no randomized controlled trials for the treatment of rare interstitial lung disease in newborns. Exogenous surfactant has been tried in some cases2,5 and provided a transient improvement in lung function, as with our patient, but it is not a viable long-term treatment option; moreover, surfactant replacement therapy does not correct the intracellular defects present in these disorders.
The use of systemic corticosteroids, hydroxychloroquine and azithromycin has been reported to be useful in isolated cases7,8 but in our patient neither the modulation of inflammatory response by this triple therapy nor any other therapeutic drug strategy had a positive long term effect on the clinical course. At present the only available curative treatment is lung transplantation, but it is rarely feasible due to scarcity of available compatible donors and limited post-transplant life span (51% 5-year survival).7
In this case, like in others5,7 where a term newborn starts with symptoms of SDR and ends up with respiratory failure, supportive therapy is needed, including ECMO, which was started in the belief that the process could be reversible. Despite the physicians’ best efforts to use ECMO only in cases with a reasonable chance of recovery, circumstances may change over time. Reaching a diagnosis that is incompatible with life alters the prognosis and makes these goals unattainable. ECMO support may result in an ethical dilemma: keeping patients alive with sophisticated technology resources when there is no chance of survival, even when the infant has an apparently normal neurological development, as in our case.
With the increasing use of ECMO in neonatal respiratory distress, an early suspicion of such diagnosis might help limit the duration of futile therapies.
Conflict of interestThe authors have no conflict of interest.
We gratefully acknowledge the assistance of Professor Dr. Mathias Griese (Department of Paediatric Pneumology of the University of Munich), Dr. Kenneth Palmer (Karolinska Institute's ECMO Unit in Sweden), Dr. Teresa Bandeira (Paediatric Pneumology Department in Hospital Santa Maria, Lisbon) and Dr. Patrícia Dias (Genetics Department in Hospital Santa Maria, Lisbon) for clinical and laboratorial guidance throughout the evolution of this child.